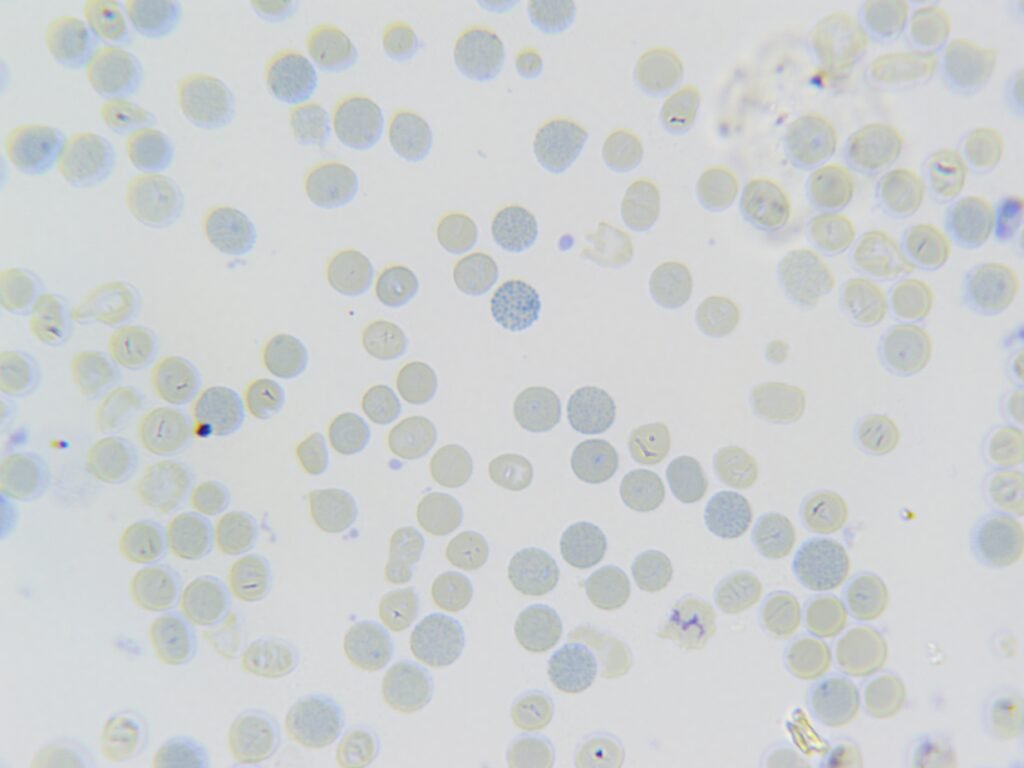
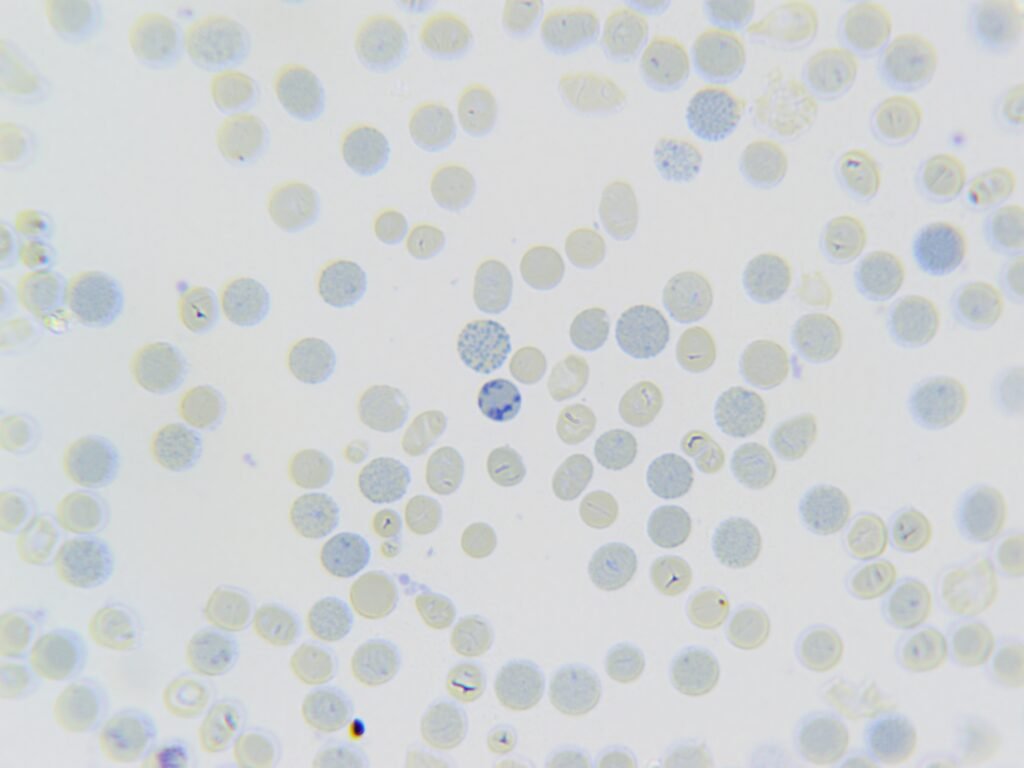

This week’s Morphology Monday featured a 35-year-old patient presenting with anaemia, fatigue, and mild splenomegaly. The FBC showed:
- Hb: 102 g/L
- MCV: 59 fL
- MCH: 18 pg
- RDW: 24.6%

The blood film, stained with a supravital stain, revealed distinctive “golf ball” inclusions, blue precipitates within red cells. These represent HbH inclusion bodies, confirming the diagnosis of HbH disease, a form of alpha thalassaemia caused by deletion or inactivation of three alpha-globin genes.